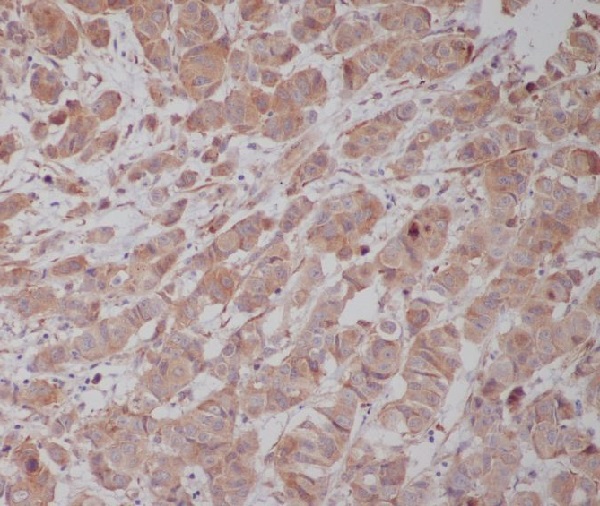

别名:TUBG1; TUBG; Tubulin gamma-1 chain; Gamma-1-tubulin; Gamma-tubulin complex component 1; GCP-1应用:WB,IHC,ICC,FCM,IP
反应种属:Human,Mouse,Rat,Monkey,Chicken,Hamster,Cow,Dog,Fish,Xenopus,Tropicalis
规格:50μl/100μl
| Description |
|---|
| TUBG1 Tubulin is the major constituent of microtubules. Gamma tubulin is found at microtubule organizing centers (MTOC) such as the spindle poles or the centrosome. Pericentriolar matrix component that regulates alpha/beta tubulin minus-end nucleation, centrosome duplication and spindle formation. Interacts with GCP2 and GCP3. Interacts with B9D2. Interacts with CDK5RAP2; |
| Specification | |
|---|---|
| Aliases | TUBG1; TUBG; Tubulin gamma-1 chain; Gamma-1-tubulin; Gamma-tubulin complex component 1; GCP-1 |
| Entrez GeneID | 7283 |
| Swissprot | P23258 |
| WB Predicted band size | Calculated MW: 51 kDa; Observed MW: 48 kDa |
| Host/Isotype | Rabbit IgG |
| Storage | Store at 4°C short term. Aliquot and store at -20°C long term. Avoid freeze/thaw cycles. |
| Species Reactivity | Human,Mouse,Rat,Monkey,Chicken,Hamster,Cow,Dog,Fish,Xenopus,Tropicalis |
| Immunogen | A synthesized peptide derived from human Tubulin gamma |
| Formulation | Rabbit IgG in phosphate buffered saline , pH 7.4, 150mM NaCl, 0.02% sodium azide and 50% glycerol. |
| Application | |
|---|---|
| IP | 1/20 |
| WB | 1/500-1/1000 |
| IHC | 1/50-1/100 |
| ICC | 1/50-1/200 |
| FCM | 1/50-1/100 |
![]() |
Western blot analysis of Tubulin gamma in (1) HeLa lysates; (2) NIH 3T3 lysates; (3) C6 lysates; (4) Zebrafish lysates; (5) COS1 lysates; (6) MDCK lysates using gamma Tubulin antibody. |
![]() |
Immunohistochemistry analysis of paraffin-embedded Human breast cancer using Tubulin gamma antibody.High-pressure and temperature Sodium Citrate pH 6.0 was used for antigen retrieval. |
本公司的所有产品仅用于科学研究或者工业应用等非医疗目的,不可用于人类或动物的临床诊断或治疗,非药用,非食用。
暂无评论
本公司的所有产品仅用于科学研究或者工业应用等非医疗目的,不可用于人类或动物的临床诊断或治疗,非药用,非食用。
中文

发表回复